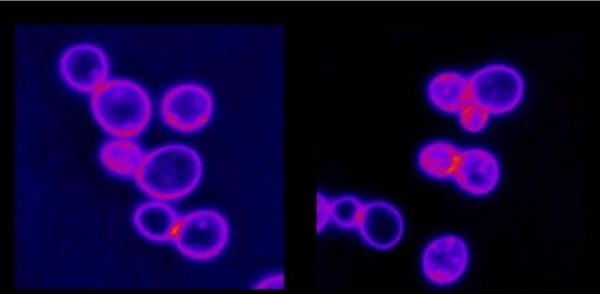

In a study using yeast cells and data from cancer cell lines, Johns Hopkins University scientists report they have found a potential weak spot among cancer cells that have extra sets of chromosomes, the structures that carry genetic material. The vulnerability, they say, is rooted in a common feature among cancer cells — their high intracellular protein concentrations — that make them appear bloated and overstuffed, and which could be used as possible new targets for cancer treatments.
“Scientists are now thinking more about targeting the biophysical properties of cancer cells to make them self-destruct,” says Rong Li, Ph.D., Bloomberg Distinguished Professor of Cell biology and Oncology at the Johns Hopkins University School of Medicine and of Chemical and Biomolecular Engineering at the Johns Hopkins Whiting School of Engineering.
Further research is planned to confirm the findings in animal and human cancer cells, says Li.
A report on the research, led by Li, is published in the June 6 issue of Nature.
Read more at Johns Hopkins Medicine
Image: Aneuploid yeast cells on the left have difficulty drawing in fluorescent molecules. Whereas, the normal yeast cells on the right are able to rapidly draw them in. (Credit: Rong Li and Hung-Ji Tsai)